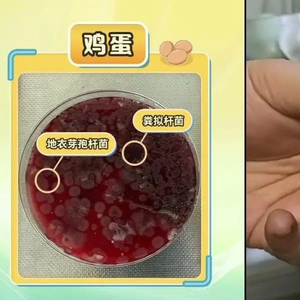

转自:央视财经微信公众号
冰箱是给食物保鲜防腐用的
不少人把它当“万能库房”
有些食物一放就是一两周
不合理存放
易加速变质、危害健康
如何科学用冰箱?
新鲜食品如何存放?

建议将鸡蛋放在冰箱门内侧的鸡蛋格或抽屉中,这样既可以避免鸡蛋因碰撞而破损,又能确保鸡蛋处于相对稳定的温度环境中。
水果
苹果等耐储存的水果可以放在阴凉通风处。热带水果,如香蕉、荔枝等,不宜放入冰箱保存,以免冻伤。
注意:水果放入冰箱前,应用保鲜膜或保鲜袋密封好,以防水分流失和串味。
新买来的肉馅
分成小份,用保鲜袋密封好,放入冰箱冷藏室保存。这样可以避免肉馅因反复解冻而导致营养流失和细菌滋生。
注意:尽快食用避免长时间存放;需要长时间保存的肉馅,应放入冷冻室,并在食用前提前放置在冷藏室解冻。
包装食品如何存放?

酱类食品
开封后尽快食用,黄豆酱、甜面酱等可保存较长时间,但也要在保质期内食用完毕。沙拉酱、番茄酱等则建议开封后一周内食用完毕。
未开封的酱类食品放在阴凉干燥处,避免阳光直射。
已开封的酱类食品应密封好,放入冰箱冷藏室保存。
饮料
开封后的饮料,应尽快饮用完毕,或密封好放入冰箱冷藏室保存。
冷冻肉类如何存放?

猪肉一般不要存放超过3个月,牛羊肉尽量不要超过9个月。长时间冷冻会导致肉类口感变差、营养流失,甚至可能产生有害物质。
存放方法
将肉类分成小份,用保鲜袋密封好,放入冰箱冷冻室保存。这样可以避免肉类因反复解冻而导致营养流失和细菌滋生。同时,也方便取用和保存。